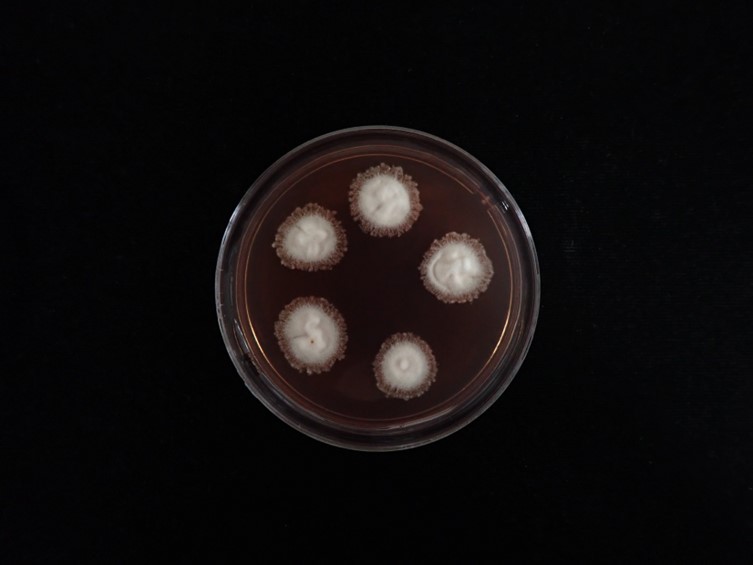

Holotype:
THAILAND, Songkhla Province, Khao Nam Khang National Park, 15 Dec. 2022, B. Sakolrak, W. Himaman, P. Jangsantear, holotype BBH49635, ex-type living culture BCC 95818.
Habitat:
Underside of a dicotyledonous leaf
Host:
Spider eggs
Description:
 White to cream and cottony mycelium forming on spider egg sacs. Conidiophores mono- or synnematous.
White to cream and cottony mycelium forming on spider egg sacs. Conidiophores mono- or synnematous. Conidiogenous cells directly from the hyphae, cylindrical, > 420 µm long, 15–20 µm wide, bearing a rather irregularly, geniculate rachis. Two types of
 conidia: Type I (microconidia), produced on specimen, forming singly on denticles, ovoid to ellipsoidal with an apiculus, occasionally cylindrical with rounded ends, aseptate, hyaline, smooth-walled, 4–7 × 2–3 µm; Type II (macroconidia) produced on solid media (OA and PDA), fusiform, smooth-walled, 10–19 × 1.5–2 µm
conidia: Type I (microconidia), produced on specimen, forming singly on denticles, ovoid to ellipsoidal with an apiculus, occasionally cylindrical with rounded ends, aseptate, hyaline, smooth-walled, 4–7 × 2–3 µm; Type II (macroconidia) produced on solid media (OA and PDA), fusiform, smooth-walled, 10–19 × 1.5–2 µm
Culture characteristics:
Colonies on PDA attaining a diam of 10–12 mm in 20 d at 25 °C, cottony with high mycelium density, white, moderate purplish red to dark purplish pink pigment diffusing in the medium.
Colonies on PDA attaining a diam of 10–12 mm in 20 d at 25 °C, cottony with high mycelium density, white, moderate purplish red to dark purplish pink pigment diffusing in the medium.  Conidiogenous cells on PDA arising from aerial hyphae, solitary.
Conidiogenous cells on PDA arising from aerial hyphae, solitary.  Conidia on PDA hyaline, fusiform, 10–19 × 1.5–2 µm.
Conidia on PDA hyaline, fusiform, 10–19 × 1.5–2 µm.
Reference:
N. Kobmoo, K. Tasanathai, J.P.M. Araújo, et al. (2023). New mycoparasitic species in the genera Niveomyces and Pseudoniveomyces gen. nov. (Hypocreales: Cordycipitaceae), with sporothrix-like asexual morphs, from Thailand . FUSE12: 91–110.
DOI: http://doi.org/10.3114/fuse.2023.12.07Species |
Strain |
Compound |
Pubchem CID |
Biological activity |
Reference |
|---|
|
Strain |
|---|
| BCC 95818 |